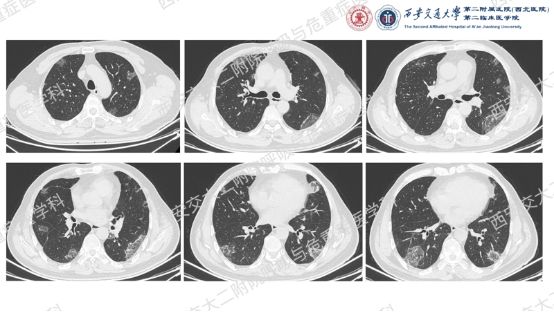

电话:029-87679000(总机)
地址:陕西省西安市西五路157号
邮编:710114
网址:www.2yuan.xjtu.edu.cn

电话:029-87679000(总机)
地址:陕西省西安市西五路157号
邮编:710114
网址:www.2yuan.xjtu.edu.cn

影像方寸藏玄机,同影异病辨真章。前几期我们一直在探索弥漫性囊性肺疾病的诊断,这一期我们切换到不同的影像模式,挖掘一下弥漫性肺部阴影的鉴别诊断。让我们继续乘风破浪,抽丝剥茧,解锁临床那些有意思的病例谜题吧!
阅影探案

析病寻踪
结合以上病史及胸部CT,您的初步考虑?